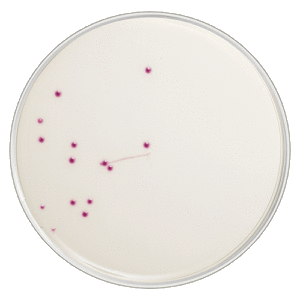
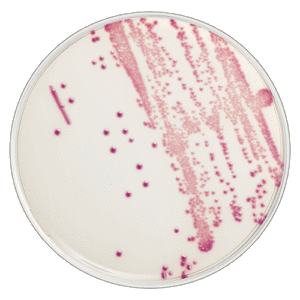

Contact us
ID Flexicult®
Flexicult® ID is a chromogenic agarplate used for identification and quantification of pathogenic bacteria for urinary tract infections.
ID Flexicult® is an agarplate used for cultured urinalysis. It provides the possibility to identify both the bacteria and quantification at the same time.
Depending on the colour, size, and amount of colonies the bacteria species can be determined.
For example the E.coli will grow as large red colonies where Enterobactor species will grow as big dark blue/violet colonies.

How to use
- Patient with symptoms of urinary tract Infections provides a urine sample
- Mark the sample with patient ID and date for collection
- The sample is spread with a 10 uL inoculum
- Add the lid and place the plate bottom up in the incubater at 35 oC over night
- Read the plate after 16-24 hours incubation
Interpretation of colony forming units pr mL urine
The amount of colony forming units/ mL is interpreted according to the picture guidelines in the IFU (Instruction for Use can be found under downloads in the bottom of this page). if more than one type of bacteria grows on the place, please interpret all of them separately.
Example:

Product range
| Item number | Product | Unit |
|---|---|---|
| 67444 | ID Flexicult ® | 10 pcs. |
Get in touch
If you have any questions, comments, or collaboration inquiries, you are very welcome to reach out.
Please fill in the form and we will get back to you as soon as possible.